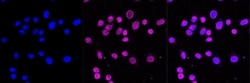
Invitrogen OLIG1 Recombinant Rabbit Monoclonal Antibody (23GB2350), Invitrogen

missing translation for 'onlineSavingsMsg'
Learn More
Learn More
Invitrogen™ OLIG1 Recombinant Rabbit Monoclonal Antibody (23GB2350), Invitrogen™
Rabbit Recombinant Monoclonal Antibody
Brand: Invitrogen™ MA552505
This item is not returnable.
View return policy
Description
OLIG1 (oligodendrocyte transcription factor 1) promotes formation and maturation of oligodendrocytes - especially in the brain. It cooperates with OLIG2 to establish the pMN domain of the embryonic neural tube.
Specifications
| OLIG1 | |
| Recombinant Monoclonal | |
| 0.391 mg/mL | |
| PBS with 50% glycerol and 0.02% sodium azide; pH 7.4 | |
| Q8TAK6, Q9JKN5, Q9WUQ3 | |
| OLIG1 | |
| A synthesized peptide derived from human Olig1 (200-271AA). | |
| 20 μL | |
| Primary | |
| Human, Mouse, Rat | |
| Antibody | |
| IgG |
| Western Blot, Immunocytochemistry | |
| 23GB2350 | |
| Unconjugated | |
| OLIG1 | |
| AI836478; AW494459; basic domain, helix-loop-helix protein, class B, 6; BHLHB6; bHLHb7; bHLHe20; bHLHe21; class B basic helix-loop-helix protein 6; Class E basic helix-loop-helix protein 21; LOW QUALITY PROTEIN: oligodendrocyte transcription factor 1; Olg1; Olg-1; Olg-1 bHLH protein; OLIG1; olig2; olig3; Oligo1; Oligo2 antibody; oligodendrocyte lineage transcription factor 1; oligodendrocyte transcription factor 1; Oligodendrocyte-specific bHLH transcription factor 1 | |
| Rabbit | |
| Affinity chromatography | |
| RUO | |
| 116448, 50914, 60394 | |
| -20°C | |
| Liquid |
Product Content Correction
Your input is important to us. Please complete this form to provide feedback related to the content on this product.
Product Title
Spot an opportunity for improvement?Share a Content Correction